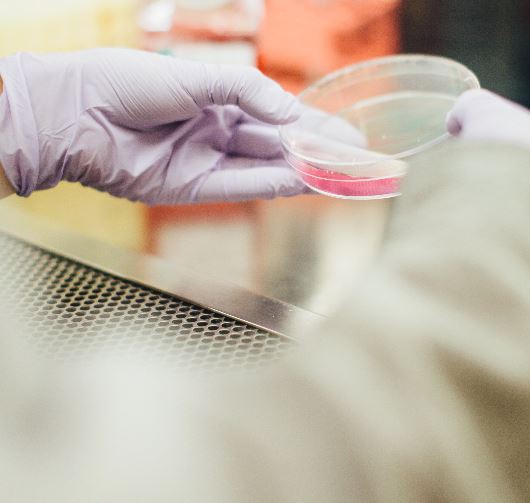

Expanding range and reach: Frontier Nutrition to extend Bangladesh malnutrition fight amid funding boost
Fortified snack firm Frontier Nutrition has detailed how it will expand its product range, increase distribution and build production facilities in the country as it strives to help tackle malnutrition